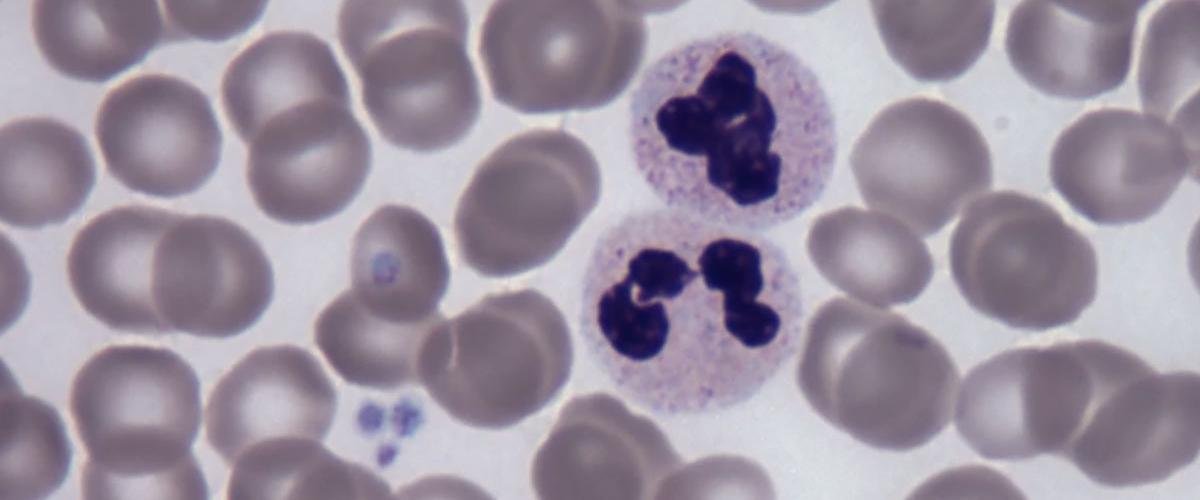
TODO:

Известно, что гемопоэтические стволовые клетки (ГСК) находятся в костном мозге и вырабатывают клетки крови и иммунные клетки. Когда в организм проникает инфекция, они повышают объемы производства, чтобы отразить нападение. Однако ученые не могли понять, как ГСК защищают сами себя, работая сверхурочно, пишет New Atlas.
«Мы знаем, что воспалительные процессы запускают гемопоэтические стволовые клетки для быстрого производства иммунных клеток и борьбы с инфекцией, — пояснил Камиль Кранк, соавтор исследования. — Однако, эти пути могут постепенно истощить стволовые клетки или вызвать их преждевременное старение, и важно понять, как это можно было бы остановить».
В своем исследовании специалисты из Университета Эдинбурга и Лондонского университета королевы Марии идентифицировали белок YTHDF2, который отвечает за эту важную работу. Когда инфекция проникает в организм, ГСК вырабатывает намного больше иммунных клеток, но в то же время начинаются воспалительные процессы, которые могут повредить стволовые клетки.
Ученые выяснили, что YTHDF2 регулирует гены, которые контролируют эти воспалительные процессы и защищает стволовые клетки от преждевременного старения.
Для того чтобы исследовать роль YTHDF2, они провели эксперимент на мышах с дефицитом этого белка, введя им вещество, действующее как вирусная инфекция. ГСК грызунов поразило хроническое воспаление, изменив выработку различных типов клеток крови. Любопытно то, что кровь молодых мышей стала напоминать кровь старых.
Эти выводы согласуются с полученными ранее данными опытов с переливанием крови молодых животных старым для улучшения состояния их здоровья и даже для замедления развития болезни Альцгеймера. Дальнейшие исследования позволят определить, можно ли замедлить старение, манипулируя уровнем белка YTHDF2.
Недавно американские биологи и биоинженеры открыли ключевые механизмы старения. Выделив два отдельных пути, которые проходят клетки в ходе возрастных изменений, они разработали новый способ генетического программирования этих процессов, который позволит увеличить продолжительность жизни.